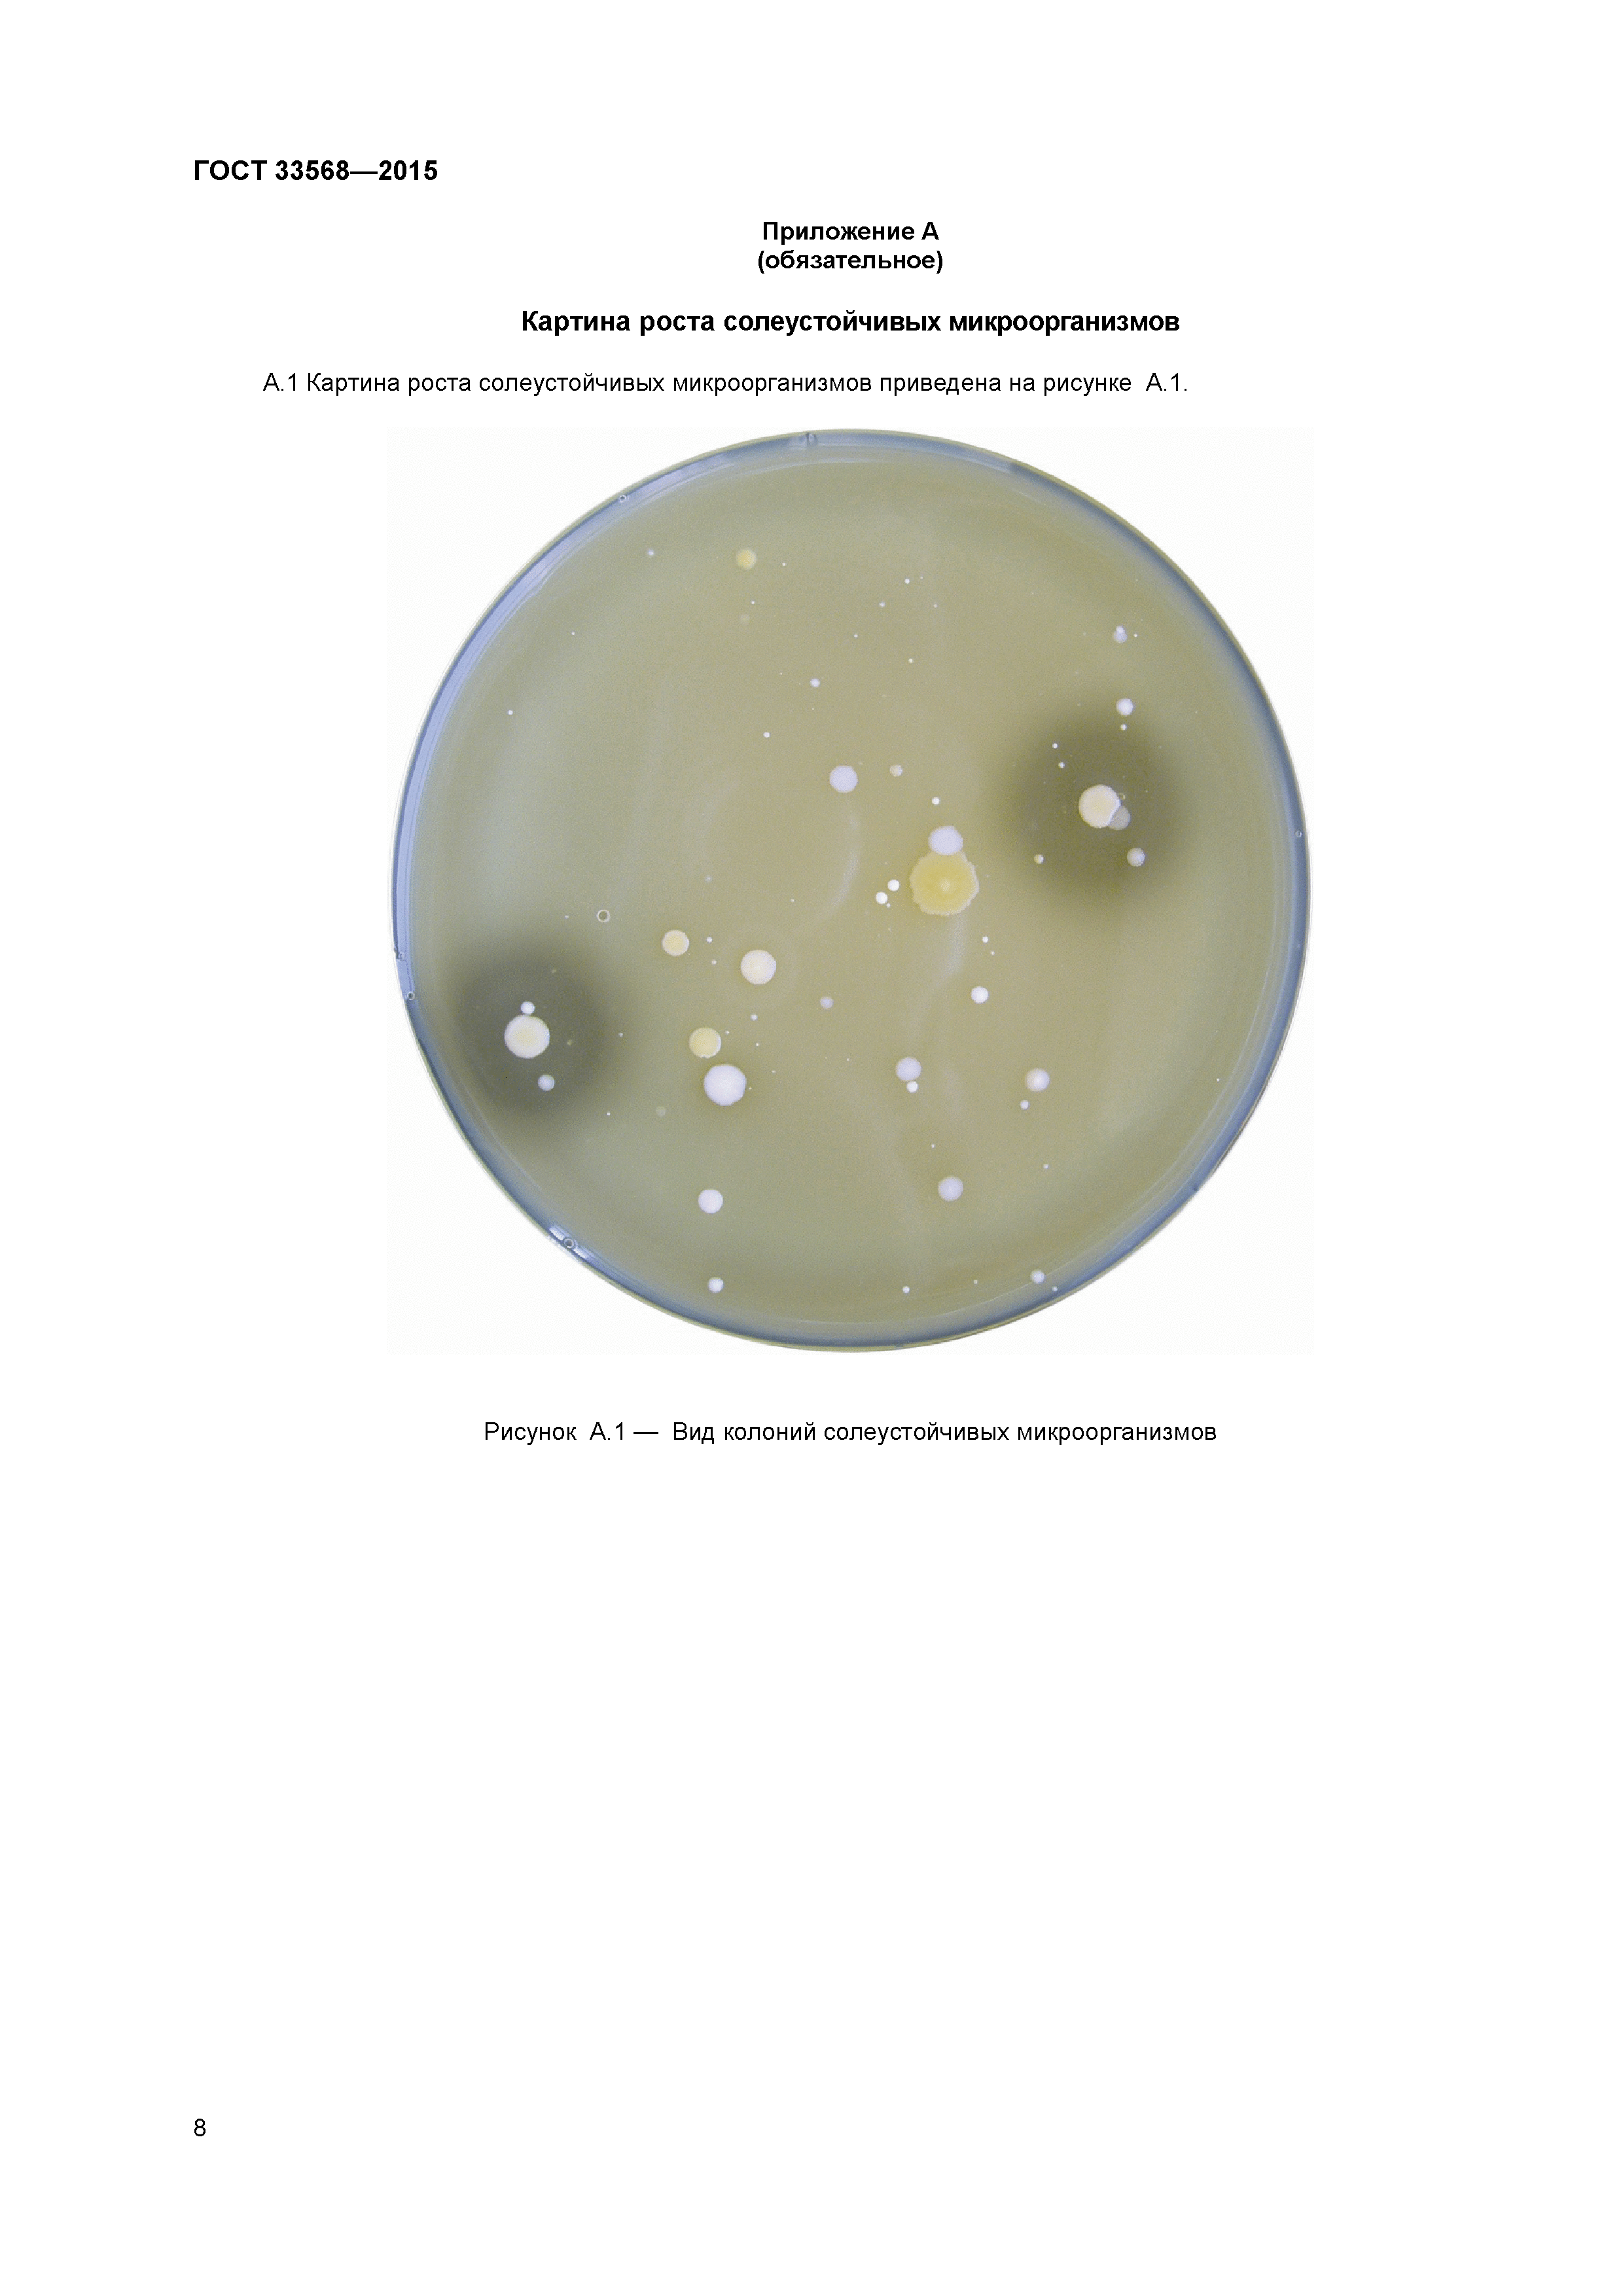
ГОСТ 33568-2015

Скачать ГОСТ 33568-2015 Молоко и молочная продукция. Методы определения солеустойчивых микроорганизмовДата актуализации: 01.01.2021 ГОСТ 33568-2015
Молоко и молочная продукция. Методы определения солеустойчивых микроорганизмов| Обозначение: | ГОСТ 33568-2015 | | Обозначение англ: | GOST 33568-2015 | | Статус: | введен впервые | | Название рус.: | Молоко и молочная продукция. Методы определения солеустойчивых микроорганизмов | | Название англ.: | Milk and dairy products. Methods for determination of salt-tolerant bacteria | | Дата добавления в базу: | 01.02.2017 | | Дата актуализации: | 01.01.2021 | | Дата введения: | 01.07.2016 | | Область применения: | Стандарт распространяется на молоко и молочную продукцию и устанавливает методы определения технически вредных солеустойчивых микроорганизмов, в том числе потенциально опасных для здоровья потребителей, стафилококков. | | Оглавление: | 1 Область применения 2 Нормативные ссылки 3 Термины и определения 4 Отбор проб 5 Метод определения общего количества солеустойчивых микроорганизмов 6 Метод выявления наличия/отсутствия стафилококков в нормируемых разведениях молочной продукции 7 Требования безопасности Приложение А (обязательное) Картина роста солеустойчивых микроорганизмов Приложение Б (обязательное) Вид колоний солеустойчивых микроорганизмов при определении каталазной активности Приложение В (обязательное) Микропрепараты стафилококков и микрококков Библиография | | Разработан: | ФГБНУ ВНИМИ ФГБНУ ВНИИМС
| | Утверждён: | 12.11.2015 Межгосударственный Совет по стандартизации, метрологии и сертификации (Inter-Governmental Council on Standardization, Metrology, and Certification 82-П) 08.12.2015 Федеральное агентство по техническому регулированию и метрологии (2118-ст)
| | Издан: | Стандартинформ (2016 г. )
| | Нормативные ссылки: |   ГОСТ 12.1.004-91 «Система стандартов безопасности труда. Пожарная безопасность. Общие требования»  ГОСТ 12.1.019-79 «Система стандартов безопасности труда. Электробезопасность. Общие требования и номенклатура видов защиты»  ГОСТ 12.4.009-83 «Система стандартов безопасности труда. Пожарная техника для защиты объектов. Основные виды. Размещение и обслуживание»  ГОСТ 12.4.021-75 «Система стандартов безопасности труда. Системы вентиляционные. Общие требования»  ГОСТ 28498-90 «Термометры жидкостные стеклянные. Общие технические требования. Методы испытаний»  ГОСТ 4233-77 «Реактивы. Натрий хлористый. Технические условия»  ГОСТ 6709-72 «Вода дистиллированная. Технические условия»  ГОСТ 12026-76 «Бумага фильтровальная лабораторная. Технические условия» ГОСТ 13805-76 «Пептон сухой ферментативный для бактериологических целей. Технические условия» ГОСТ 13928-84 «Молоко и сливки заготовляемые. Правила приемки, методы отбора проб и подготовка их к анализу» ГОСТ 14919-83 «Электроплиты, электроплитки и жарочные электрошкафы бытовые. Общие технические условия» ГОСТ 17206-96 «Агар микробиологический. Технические условия» ГОСТ 1770-74 «Посуда мерная лабораторная стеклянная. Цилиндры, мензурки, колбы, пробирки. Общие технические условия»  ГОСТ 177-88 «Водорода перекись. Технические условия» ГОСТ 19881-74 «Анализаторы потенциометрические для контроля рН молока и молочных продуктов. Общие технические условия» ГОСТ 25336-82 «Посуда и оборудование лабораторные стеклянные. Типы, основные параметры и размеры» ГОСТ 25706-83 «Лупы. Типы, основные параметры. Общие технические требования» ГОСТ 27752-88 «Часы электронно-механические кварцевые настольные, настенные и часы-будильники. Общие технические условия» ГОСТ 29169-91 «Посуда лабораторная стеклянная. Пипетки с одной отметкой»  ГОСТ 29227-91 «Посуда лабораторная стеклянная. Пипетки градуированные. Часть 1. Общие требования» ГОСТ 4328-77 «Реактивы. Натрия гидроокись. Технические условия» ГОСТ 5556-81 «Вата медицинская гигроскопическая. Технические условия» ГОСТ 9284-75 «Стекла предметные для микропрепаратов. Технические условия» ГОСТ 490-2006 «Добавки пищевые. Кислота молочная Е270. Технические условия»  ГОСТ Р 12.1.019-2009 «Система стандартов безопасности труда. Электробезопасность. Общие требования и номенклатура видов защиты» ГОСТ ISO 11133-1-2011 «Микробиология пищевых продуктов и кормов для животных. Руководящие указания по приготовлению и производству культуральных сред. Часть 1. Общие руководящие указания по обеспечению качества приготовления культуральных сред в лаборатории» ГОСТ 31658-2012 «Молоко обезжиренное-сырье. Технические условия» ГОСТ OIML R 76-1-2011 «Государственная система обеспечения единства измерений. Весы неавтоматического действия. Часть 1. Метрологические и технические требования. Испытания»  Технический регламент Таможенного союза 033/2013 «О безопасности молока и молочной продукции»  ГОСТ 26809.1-2014 «Молоко и молочная продукция. Правила приемки, методы отбора и подготовка проб к анализу. Часть 1. Молоко, молочные, молочные составные и молокосодержащие продукты»  ГОСТ 26809.2-2014 «Молоко и молочная продукция. Правила приемки, методы отбора и подготовка проб к анализу. Часть 2. Масло из коровьего молока, спреды, сыры и сырные продукты, плавленые сыры и плавленые сырные продукты»  ГОСТ 32901-2014 «Молоко и молочная продукция. Методы микробиологического анализа»  ГОСТ 1.2-2009 «Межгосударственная система стандартизации. Стандарты межгосударственные, правила и рекомендации по межгосударственной стандартизации. Правила разработки, принятия, применения, обновления и отмены»  ГОСТ 1.0-92 «Межгосударственная система стандартизации. Основные положения»
|
|